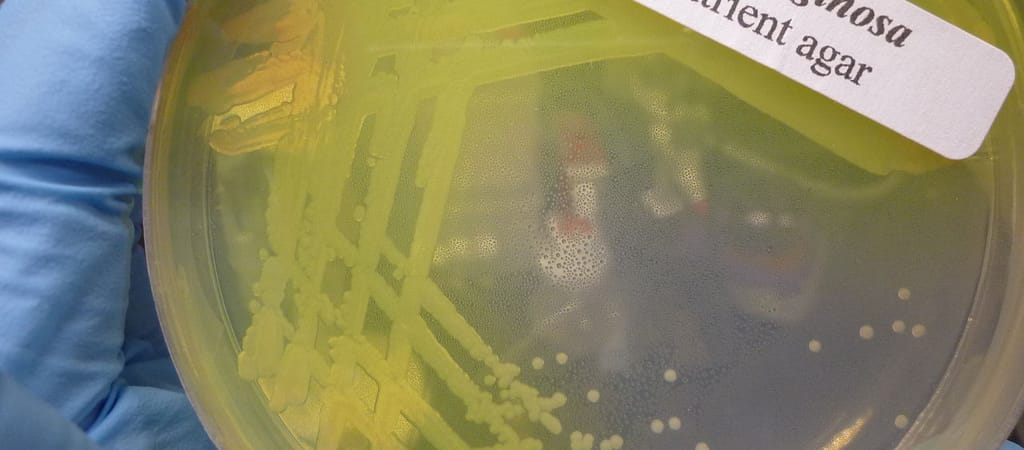

Egyelőre nem tudják, honnan és hogyan került a vezetékekbe.
Rossz hír a székesfehérvári Vidi-stadion látogatóinak: olyan szuperbaktériumot találtak az épület ivóvízhálózatában, amely ellenáll az antibiotikumoknak.
A mérések a pseudomonas aeruginosa nevű kórokozót mutatták ki, amely az úgynevezett kórházi baktériumok közé tartozik, azaz ott okoz leginkább bajt, amikor legyengült immunrendszerű, beteg vagy idős szervezetbe jut. Leginkább a tüdőt támadja meg, de megfertőzi a vért, a bőrt, a csontokat, a fület, a húgyutakat és a szívbillentyűket is.
A pseudomonas aeruginosát az Egészségügyi Világszervezet (WHO) listáján az legveszélyesebb rezisztens baktériumok között találjuk.
A fertőzöttség a szokásos rutinellenőrzés során derült ki. Az Indexnek küldött olvasói levelek szerint már 2018 decemberében, röviddel az új stadion átadását követően észrevették a problémát.
A Vidi-stadionban ballonos és palackozott vízzel igyekeznek biztosítani a a dolgozók és a vendégek vízigényét.
A fertőzés okait jelenleg vizsgálják, de mivel a pseudomonas aeruginosa cseppfertőzéssel terjed és nehezen elpusztítható, több teória is van arról, hogy került a vízvezetékekbe. A Napi.hu-nak nyilatkozó szakértő szerint a heves esőzés is ludas lehet a dologban. Vagy lakossági szennyvíz került a vezetékekbe, vagy a közeli Sós-tó vizével jutott be fertőzött rohadó szerves anyag.
A Vidi FC július 11-én rendezte volna első hazai mérkőzését az idei szezonban, viszont a helyzetre való tekintettel az UEFA megcserélte a meccsek sorrendjét, és a székesfehérváriaknak így egy héttel több ideje marad a fertőtlenítésre.
A Vidi-stadiont egy év késéssel adták át, a tervezettnél jóval drágább lett, 14,6 milliárd forintba került. A Napi.hu megkérdezte a fenntartót, hogy terveznek-e kártérítési eljárást kezdeményezni az építkezés kivitelezőivel szemben, de nem kaptak választ. A stadiont a Strabag-MML, Strabag Építő, illetve a Belfry PE Kft . közösen építette.
Perre megy a DK, hogy kiderüljön, mi történt az olimpia alatt a párizsi luxusszállodai szobákkal, amit Sulyoknak szántak
Sebián-Petrovszki László belenézhetett a szerződésekbe, azonban az adatok egy részét kitakarták, így nem derült ki, ki írta a szerződést és ki döntött róla.